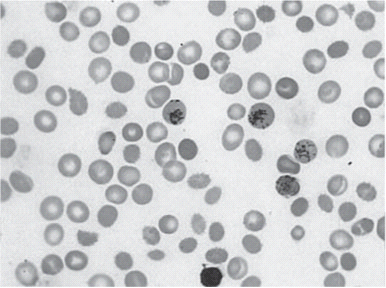
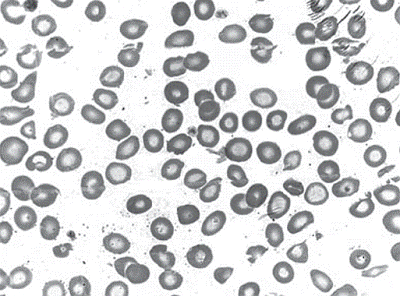
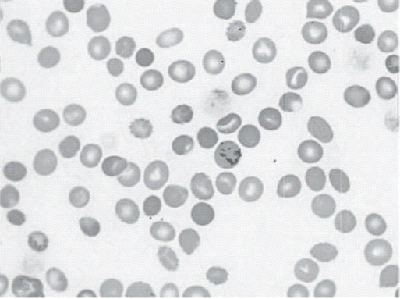
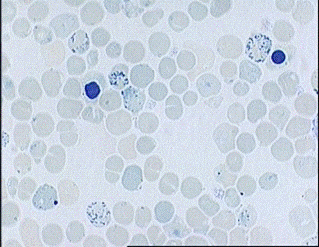

Лейкемоидные реакции. Ретикулоциты
МИНИСТЕРСТВО
ЗДРАВООХРАНЕНИЯ УКРАИНЫ
План
практического занятия
«Лейкемоидные
реакции. Ретикулоциты»
Выполнила
Лаврененко
З.Л
2012
г.
Тема: Лейкемоидные реакции. Определение
количества ретикулоцитов.
Цель занятия: изучить лейкемоидные реакции,
приобрести практические навыки проведения общего клинического анализа крови;
изучить особенности окраски и подсчета ретикулоцитов.
Структура занятия:
. Оценка исходного уровня знаний
. Разбор теоретических вопросов
. Выполнение практической лабораторной работы
. Решение тестов и ситуационных задач по данной
теме занятия
Теоретические вопросы:
I. Исходный уровень знаний
) Тесты начального уровня
2) Схема кроветворения
) Гранулоциты, их функции
) Лейкоцитарные реакции
) Теоретические навыки проведения общего
анализа крови
II. Теоретические вопросы:
) Лейкемоидные реакции - характеристика,
причины, механизмы развития, проявление в костном мозге и периферической крови,
отличие от лейкозов; классификация;
2) Лейкемоидные реакции миелоидного и
лимфоидного типа.
) Изучение в демонстрационных препаратах
морфологии клеток агранулоцитарного ряда
) Интерпретация лейкограммы
) Ретикулоциты, характеристика, метод
определения, особенности окраски крови, методы подсчета.
Практическая работа
Студенты должны уметь:
) Самостоятельно проводить общий
клинический анализ крови
2) Окрасить метиленовым синим, азуром I
и II, бриллиантовым
крезиловым синим ретикулоциты
3) Проводить подсчет ретикулоцитов, знать
интерпретацию результатов
Самостоятельная работа
) Тесты и ситуационные задачи для
самостоятельной работы
Самостоятельная работа
Проверка начального уровня знаний
Задача
Выберите правильно приготовленный мазок крови.
Аргументируйте свой ответ:

Ответ: 5

Для окраски и исследования отбираются лучшие
мазки. Хороший мазок должен отвечать следующим требованиям:
. Должен весь умещаться в пределах предметного
стекла, нигде не доходя до его границ. Он начинается у капли и сам
заканчивается на расстоянии 1-1,5 см от левого конца стекла.
. Он должен быть уже и короче стекла, т. е.
должен иметь свободные края по длине и зазубренный край по ширине в конце
мазка.
. Мазок должен быть тонким, гомогенным, без
просветов и прерывающих линий, с нежной поверхностью и без следов гемолиза.
. Края мазка должны быть ровными.
Тесты
Вариант 1
1. Локализация красного костного мозга:
а. плоские и губчатые кости
б. спинной мозг
в. грубоволокнистая костная ткань
г. все ответы верны
. Функции эритроцитов:
а. защитная
б. перенос О2
в. обезвреживание токсинов
г. продуцируют гепарин
3. Функции базофилов
а. защитная
б. перенос О2
в. обезвреживание токсинов
г. продуцируют гепарин
4. Резкое увеличение в крови бластных клеток,
отсутствие созревающих клеток и незначительное число зрелых клеток называется:
а. лейкимическая реакция
б. лейкемический провал
в. лейкопения
г. лейкоцитоз
. Из какого пальца целесообразно делать
забор крови:
а. мизинец
б. большой палец правой руки
в. 4 палец левой руки
г. средний палец левой руки
. Какой расчет производят в камере Горяева,
считая в пяти больших квадратах, разделенные на 16 маленьких:
а. лейкоциты
б. эритроциты
в. моноциты
г. все варианты верны
. Подгруппа белых клеток крови,
характеризующихся наличием крупного сегментированного ядра и присутствием в
цитоплазме специфических гранул, выявляемых в световой микроскоп при обычном
окрашивании:
а. гранулоциты
б. пойкилоциты
в. эритробласты
г. все ответы верны
. В зависимости от особенностей восприятия
гранулоцитов стандартных красителей их делят на:
а. нейтрофильные
б. эозинофильные
в. базофильные.
г. все ответы верны
. Часть объёма крови, приходящаяся на
эритроциты:
а. гематокрит
б. гемоглобин
в. эритропоэтин
г. протромбин
. Моноцитопения наблюдается при:
а. острых септических процессах
б. лучевой болезни
в. синдроме Кушинга
г. гипотиреозе
Вариант 2
. Функции нейтрофилов
а. обезвреживание чужеродных белков
б. продуцирование гепарина
в. обезвреживание токсинов
г. обеспечение иммунитета
. Функции эозинафилов
а. обезвреживание чужеродных белков
б. продуцирование гепарина
в. обезвреживание токсинов
г. обеспечение иммунитета
. Функции лимфоцитов
а. обезвреживание чужеродных белков
б. продуцирование гепарина
в. обезвреживание токсинов
г. обеспечение иммунитета
. Резкое увеличение в крови бластных клеток,
отсутствие созревающих клеток и незначительное число зрелых клеток называется:
а. лейкимическая реакция
б. лейкемический провал
в. лейкопения
г. лейкоцитоз
. Подгруппа белых клеток крови,
характеризующихся наличием крупного сегментированного ядра и присутствием в
цитоплазме специфических гранул, выявляемых в световой микроскоп при обычном
окрашивании:
а. гранулоциты
б. пойкилоциты
в. эритробласты
г. все ответы верны
. Из какого пальца целесообразно делать
забор крови:
а. мизинец
б. большой палец правой руки
в. 4 палец левой руки
г. средний палец левой руки
. Клетка предшественница тромбоцита:
а. мегакариоцит
б. промегакариоцит
в. ретикулоцит
г. промиелоцит
. Клональное злокачественное
(неопластическое) заболевание кроветворной системы:
а. лимфома
б. лейкоз
в. анемия
г. гранулематоз
. Замещение кроветворной ткани костного
мозга соединительной называется:
а. миелофиброз
б. миелиноз
в. лейкимия
г. нет правильного ответа
. Клетка предшественница моноцита
а. миелобласт
б. промиелоцит
в. промегокариоцит
г. эритроцит
Раздел I
Лейкемоидные реакции - состояния,
характеризующиеся изменениями в крови, органах гемопоэза и организме в целом,
сходные с теми, которые наблюдаются при гемобластозах, главным образом - при
лейкозах.
Своё название - «лейкемоидные» - эти реакции
получили в связи с тем, что изменения в гемопоэтической ткани и в
периферической крови напоминают изменения при лейкозах. Однако лейкемоидные
реакции никогда не трансформируются в тот лейкоз, с которым они сходны
гематологически. Отличия между лейкемоидными реакциями и лейкозами приведены в
таблице ниже.
В широком смысле лейкемоидные реакции включают в
себя неопухолевые увеличение и уменьшение количества клеток в крови, необычную
морфологию клеток, а также изменения в кроветворных органах. Однако в
большинстве случаев подразумевается увеличение содержания клеток в крови
(лейкоцитоз, эритроцитоз, тромбоцитоз).
Механизмы развития лейкоцитозов:
. Клеточные механизмы регуляции лейкопоэза.
. Гуморальные.
. Гормональные.
. Нервно-рефлекторные.
Результатом является: стимуляция лейкопоэза
(увеличение выработки лейкоцитов), ускорение их выхода из костного мозга.
При инфекционных заболеваниях развитие
лейкоцитоза проходит в 3 фазы:
) НФ лейкоцитоз (начало заболевания, клеточные и
гуморальные механизмы→ гормональные).
) Моноцитарный лейкоцитоз (разгар).
) Лимфоцитарный лейкоцитоз (выздоровление).
Свойства стволовой клетки:
) Самообновление, то есть способность
сохранять неизменный фенотип после деления (без дифференцировки).
) Потентность (дифференцирующий
потенциал), или способность давать потомство в виде специализированных типов
клеток.
Механизмы развития лейкопений:
) Нарушение образования лейкоцитов (радиация,
интоксикация, аутоиммунные процессы).
) Нарушение выхода лейкоцитов в периферическую
кровь.
) Быстрое разрушение лейкоцитов.
) Перераспределение лейкоцитов в сосудистом
русле.
Отличия лейкемоидных реакций от лейкозов
|
Лейкемоидные
реакции
|
Лейкозы
|
|
ПРИЧИНЫ
|
|
-
Возбудители инфекций - БАВ, активирующие выход форменных элементов крови из
органов гемопоэза. - Состояния, ведущие к повышенному «потреблению» форменных
элементов крови - Иммунопатологические состояния
|
-
Канцерогены
|
|
МЕХАНИЗМЫ
РАЗВИТИЯ
|
|
-
Активация нормального гемопоэза и поступление в сосудистое русло избытка
форменных элементов крови - Подавление нормального гемопоэза и торможение
выхода в сосудистое русло форменных элементов крови
|
-Трансформация
нормальной гемопоэтической клетки в опухолевую
|
|
ПРОЯВЛЕНИЯ
|
|
Костный
мозг:
|
|
-
Очаговая гиперплазия нормальных гемопоэтических клеток (при пролиферативных
лейкемоидных реакциях) -Гипоплазия гемопоэтической ткани (при цитопенических
формах лейкемоидных реакций)
|
-Генерализованная
гиперплазия опухолевых гемопоэтических клеток. -Обычно (но не всегда,
например, при алейкемической форме) много бластных и незрелых лейкозных
клеток
|
|
Периферическая
кровь:
|
|
-Наличие
бластных и незрелых форм лейкоцитарного, тромбоцитарного или эритроцитарного
гемопоэза (при пролиферативных реакциях) -Лейко -, эритро - и/или
тромбоцитопения (при цитопенических лейкемоидных реакциях) - Признаки
дегенерации форменных элементов крови
|
-Цитопения
сочетается с наличием в крови бластных лейкозных клеток -Признаки дегенерации
клеток обычно отсутствуют (наблюдаются при B-лимфолейкозах) -Лейкемический
«провал» при остром миелобластном лейкозе
|
Классификация
Лейкемоидные реакции делятся на:
1. Лимфоидные
2. Моноцитарные
. Миелоидные
· нейтрофильные
· эозинофильные
· базофильные
Лейкемоидные реакции никогда не переходят в
лейкоз. Различают лейкемоидные реакции миелоидного и лимфатического типов.
РЕАКЦИИ МИЕЛОИДНОГО ТИПА
К таким реакциям относятся промиелоцитарные,
нейтрофильные со сдвигом влево, реакции двух или трех ростков миелопоэза,
моноцитарные и реактивные цитопении - лейко- и тромбоцитопении.
Промиелоцитарные реакции
Промиелоцитарные реакции могут наблюдаться при
агранулоцитозах, после появления бластных форм.
Наличие большого количества промиелоцитов с
обильной зернистостью напоминает острый промиелоцитарный лейкоз. Однако
отсутствие геморрагического синдрома, характерного для острого
промиелоцитарного лейкоза, тромбоцитопении, полиморфизм ядер промиелоцитов и их
зернистости, отрицательная реакция на сульфатированные кислые
гликозаминогликаны позволяют исключить этот диагноз.
Промиелоцитарные лейкемоидные реакции в костном мозге
могут быть обусловлены токсикоинфекцией, аллергическим дерматитом в результате
приема лекарственных средств и действием других факторов. Во всех этих случаях
отсутствуют характерные клинические и морфологические признаки как
промиелоцитарного лейкоза, так и агранулоцитоза.
Промиелоцитарные лейкемоидные реакции могут
наблюдаться при наследственных нейтропениях. Эозинофилия и моноцитоз в костном
мозге, а иногда и в крови, характерные для наследственной нейтропении, никогда
не встречаются при остром промиелоцитарном лейкозе.
Нейтрофильные реакции со сдвигом влево
Нейтрофильные реакции со сдвигом влево вплоть до
промиелоцитов наблюдаются при воспалительных и нагноительных процессах, сепсисе
и хроническом миелолейкозе. Начало хронического миелолейкоза обычно
бессимптомное, тогда как при воспалительных, нагноительных процессах и сепсисе
всегда имеется выраженная клиническая симптоматика.
Нейтрофилез со сдвигом влево имеет место при
острой кровопотере, однако в случаях присоединения токсикоинфекции, при нерезко
выраженном лейкоцитозе возможен значительный палочкоядерный сдвиг до 30-40 %
без метамиелоцитов и миелоцитов. В костном мозге при этом значительно
возрастает количество промиелоцитов, соотношение лейкоцитов и эритроцитов резко
увеличивается за счет первых. В отличие от хронического миелолейкоза, при
лейкемоидных реакциях такого типа не наблюдается увеличения количества
тромбоцитов.
Реактивная эозинофилия
Реактивная эозинофилия как проявление
аллергизации организма может отмечаться при гельминтозах, системных болезнях
соединительной ткани, раке, лимфогранулематозе и других заболеваниях. При
хроническом миелолейкозе эозинофильные гранулоциты, наряду с другими зернистыми
клетками, являются субстратом опухоли.
Реакции двух или трех ростков миелопоэза
Могут наблюдаться при метастазах рака в костный
мозг.
Выделяют два типа таких лейкемоидных реакций:
· первый характеризуется нейтрофильным
лейкоцитозом (нередко с выраженным сдвигом влево, иногда с некоторым
увеличением количества базофильных гранулоцитов), тромбоцитозом и реже
эритроцитозом;
· для второго характерны нейтрофилез
(со сдвигом до миелоцитов) и появление в периферической крови эритрокариоцитов
различной степени зрелости.
При множественных метастазах рака в костный мозг
развиваются анемия и тромбоцитопения. Количество лейкоцитов варьирует от
лейкопении до небольшого лейкоцитоза. В мазке крови - нейтрофилез со сдвигом
влево до миелоцитов и промиелоцитов, обнаруживают эритрокариоциты (этот тип
лейкемоидной реакции напоминает эритромиелоз).
Такая же картина может развиться при остром
иммунном гемолизе, для которого характерен лейкоцитоз со сдвигом нейтрофильных
гранулоцитов до миелоцитов и промиелоцитов, возможно наличие единичных
нормобластов. В периферической крови появляются ретикулярные клетки, в костном мозге
количество их может достигать 15 %.
Ретикулоцитоз в периферической крови, желтуха,
значительное количество уробилина в моче, гемоглобинурия и гемосидеринурия,
анемия, раздражение красного ростка в костном мозге при отсутствии увеличения
количества бластных клеток позволяют исключить острый эритромиелоз, при котором
также может наблюдаться гемолиз, но он не является ведущим симптомом
заболевания, как при гемолитической анемии.
Моноцитарные реакции
Моноцитарные реакции напоминают хронический
моноцитарный лейкоз, развивающийся у лиц в возрасте старше 50 лет и протекающий
без клинических проявлений на протяжении многих лет. Реактивные моноцитозы
появляются на фоне того или иного заболевания. Наиболее часто они наблюдаются
при туберкулезе, ревматизме, токсоплазмозе, наследственных нейтропениях,
парапротеинемических гемобластозах, лимфогранулематозе и других заболеваниях.
При затруднениях в диагностике показана
трепанобиопсия костного мозга. При моноцитарном лейкозе в трепанате преобладают
опухолевые клетки (клетки больших размеров с крупными светлыми ядрами,
ядрышками и часто бледно-голубой цитоплазмой).
Реактивные цитопении
К ним относятся острые лейко- и тромбоцитопении,
развивающиеся в результате быстрого потребления большого количества клеток
(цитопении потребления).
Реактивные цитопении, особенно лейкопении,
наблюдаются редко. Возникают они обычно после цитостатической терапии в
результате истощения или угнетения у таких больных костномозгового
гранулоцитарного резерва (например, у онкологических больных).
Тромбоцитопении потребления могут возникать
после инфекционного шока, при тромбозах, ДВС-синдроме с массивным потреблением
тромбоцитов и уменьшением их количества в периферической крови. Возможно
появление тромбоцитопении потребления после кровопотери. Иногда тромбоцитопении
может сопровождаться лейкоцитозом с нейтрофильным сдвигом влево и анемией.
Для дифференциации цитопений потребления и
алейкемической стадии острого лейкоза (при необходимости) исследуется пунктат
костного мозга (при цитопении потребления в нем отсутствуют клетки острого
лейкоза).
РЕАКЦИИ ЛИМФОИДНОГОГО ТИПА
К реакциям этого типа относятся малосимптомный
инфекционный лимфоцитоз, напоминающий по картине крови хронический лимфолейкоз,
и инфекционный мононуклеоз, который часто приходится дифференцировать с острым
лейкозом.
Малосимптомный инфекционный лимфоцитоз
Характеризуется высоким лейкоцитозом за счет
выраженного лимфоцитоза периферической крови при слабо выраженной клинической
симптоматике или ее отсутствии. Наиболее часто заболевают дети в возрасте от 2
до 7 лет, хотя зарегистрированы случаи заболевания и в двухмесячном возрасте, и
у лиц старше 17 лет (до 25).
Считается, что это вирусное заболевание, при
котором возбудитель проникает в организм через слизистую оболочку носовой части
глотки или пищеварительного канала. Заболевание характеризуется значительной
контагиозностью.
Клиническая симптоматика очень скудная и
проявляется кратковременно (12-24 ч). Начало заболевания внезапное или
постепенное, может проявляться болью в животе и другими признаками
энтероколита. Изредка развиваются менингеальные симптомы. Большинство больных
страдают отсутствием аппетита, быстрой утомляемостью. Нередко повышается
температура тела, появляется ринофарингит.
В некоторых случаях период нарастания симптомов остается
незамеченным. Длительность заболевания, по данным разных авторов, колеблется от
нескольких недель до трех месяцев и более.
Периферические лимфатические узлы обычно не
увеличены, но изредка возможно незначительное увеличение шейных лимфатических
узлов, иногда и небных миндалин. Описаны единичные случаи с незначительным
увеличением селезенки.
Важным диагностическим признаком заболевания
является гиперлейкоцитоз с лимфоцитозом. Количество лейкоцитов колеблется от
40-60 до 100-150 Г в 1 л. В гемограмме лимфоциты составляют 80-90 %. Это клетки
средних и малых размеров, для которых характерны уплотненная структура ядра и
светло-голубая узкая цитоплазма. Обнаруживаются двуядерные лимфоциты и
ретикулярные клетки. Количество эритроцитов и тромбоцитов остается без
изменений.
Резкое увеличение лимфоцитов в периферической
крови при отсутствии или незначительной гиперплазии лимфатических узлов,
по-видимому, можно объяснить повышенной элиминацией лимфатических клеток из
лимфоидных органов в кровь, что подтверждается гистологическим изучением
срезов. Установлено, что при малосимптомном инфекционном лимфоцитозе в
лимфатических узлах лимфатические фолликулы имеют небольшие размеры, часть из
них гиалинизирована. Это объясняется лимфотропным действием вируса.
Качественные и количественные изменения в
костном мозге не обнаруживаются. Увеличение количества лимфоцитов в миелограмме
является следствием разбавления костномозгового пунктата периферической кровью.
Картина крови при инфекционном лимфоцитозе
напоминает хронический лимфолейкоз. Однако инфекционный лимфоцитоз развивается
обычно у детей и реже в юношеском возрасте, а хронический лимфолейкоз у людей
пожилого возраста.
Инфекционный мононуклеоз
Инфекционный мононуклеоз - заболевание,
вызываемое вирусом, обладающим тропизмом к системе мононуклеарных фагоцитов, и
особенно к лимфатической ткани.
Впервые это заболевание было описано в 1885 г.
русским педиатром Н. Ф. Филатовым. Среди острых лимфаденитов он выделил
самостоятельную нозологическую форму под названием «идиопатический лимфаденит».
В 1889 г. Пфейффер описал это же заболевание под названием «железистая
лихорадка». Существует много синонимов названия данного заболевания, однако
общепринятым в настоящее время и отражающим морфологическую сущность процесса
является «инфекционный мононуклеоз».
Развивается инфекционный мононуклеоз во всех
возрастных группах, но наиболее часто - у подростков, юношей и у молодых людей.
Чаще всего болеют лица мужского пола. Заболеваемость возрастает осенью и
весной.
Симптомы инфекционного мононуклеоза
Заболевание может начинаться с появления всех
основных клинических симптомов:
· Лихорадки;
· Ангины;
· Лимфаденопатии;
· Спленомегалии - или только одного из
них.
Повышение температуры тела обычно предшествует
ангине и лимфаденопатии. Ангина наблюдается у 90 % больных инфекционным
мононуклеозом и может быть катаральной, язвенно-некротической и
псевдодифтеритической. Лимфаденопатия при инфекционном мононуклеозе более
ранний и постоянный симптом, чем ангина, и только в редких случаях она
появляется после ангины.
Величина лимфатических узлов варьирует от
размеров фасоли до грецкого ореха и более. Иногда они едва прощупываются либо
совсем не увеличены. Наиболее характерно увеличение лимфатических узлов у
заднего края грудно-ключично-сосцевидной мышцы; увеличиваются также передние
шейные подчелюстные, подмышечные, паховые и другие лимфатические узлы
Возможно увеличение лимфатических узлов
средостения и брюшной полости. Наибольших размеров они достигают к 4-6-му дню
заболевания, к 10- 15-му обычно уменьшаются в размерах, однако незначительное
увеличение лимфатических узлов можно наблюдать в течение многих недель и
месяцев. Консистенция лимфатических узлов упругая, они не спаяны между собой и
с кожей, слегка болезненны при отнятии пальцев во время пальпации.
Увеличение селезенки, как правило,
незначительное. Описаны случаи спленомегалической формы инфекционного
мононуклеоза. Уменьшение размеров селезенки до нормы происходит очень медленно.
Увеличение печени на 10- 30 мм наблюдается у большинства больных инфекционным
мононуклеозом. В отдельных случаях имеет место желтуха.
Описанная клиническая картина заболевания
наблюдается приблизительно в 50 % случаев. У других больных процесс
характеризуется большим разнообразием клинической симптоматики.
Диагностика инфекционного мононуклеоза
Диагноз инфекционного мононуклеоза ставится на
основании морфологического исследования крови. Основными гематологическими
признаками заболевания являются умеренный лейкоцитоз и преобладание
мононуклеаров и их атипичных форм в периферической крови.
Лейкоцитоз при инфекционном мононуклеозе
варьирует в пределах 10 - 20 Г в 1 л, однако возможны и более значительное
повышение, и случаи, протекающие с лейкопенией. У детей младшего возраста
лейкоцитоз выше, чем у старших детей и подростков. Наиболее значительный
лейкоцитоз наблюдается между 5-м и 12-м днями заболевания. Продолжительность
лейкоцитоза может быть от двух недель до нескольких месяцев.
Количество лимфоцитов в гемограмме в пределах
нормы или увеличено до 50-70 % за счет средних и больших, широкоцитоплазменных,
лимфоцитов. Отмечается небольшой моноцитоз, но возможно и нормальное количество
моноцитов.
Особый интерес представляют атипичные
мононуклеары, которые в ряде случаев могут быть многочисленными и
разнообразными.

Размеры этих клеток варьируют от среднего
лимфоцита до большого моноцита, чаще всего от 15 до 30 мкм.
Они округлой или овальной формы. Цитоплазма по
сравнению с ядром обильная и характеризуется голубой окраской, более
интенсивной на периферии клетки и светлой вокруг ядра. Ненормальная базофилия
цитоплазмы атипичных мононуклеаров, по мнению многих авторов - наиболее важный
признак этого заболевания.
Встречаются клетки с бледно-голубой, как бы
вымытой цитоплазмой. В некоторых клетках можно обнаружить азурофильную
зернистость. Ядро чаще всего располагается эксцентрично, оно округлой формы,
окончатое, дву- или трехдольчатое. Хроматин ядра может располагаться
беспорядочно либо в виде спиц, как у плазматических клеток; возможно
расположение хроматина в виде нежной сети. Некоторые исследователи называют эти
клетки лимфомоноцитами, учитывая их сходство одновременно с лимфоцитами
(размеры клеток, форма ядра) и с моноцитами (структура ядра).
В цитоплазме мононуклеаров обнаружены включения
(мелкие осколки ядра), которые многими рассматриваются как характерный признак
инфекционного мононуклеоза. Атипичные мононуклеары называют вироцитами. Они не
являются специфическими только для инфекционного мононуклеоза, так как могут
наблюдаться при сывороточной болезни, гриппе, инфаркте миокарда, краснухе и
других заболеваниях, но содержание их при этом невысокое (до 10 %), а при
инфекционном мононуклеозе они встречаются в большом количестве.
Кроме вироцитов и типичных мононуклеаров, в
периферической крови при инфекционном мононуклеозе появляются бластные клетки -
иммунобласты величиной 15-18 мкм, по структуре ядра, наличию ядрышка и
базофилии цитоплазмы они напоминают лимфобласт или плазмобласт.
Кроме иммунобластов, обнаруживаются плазмоциты,
количество которых может достигать 20 % и более. При подсчете гемограммы
отмечаются лимфоциты (малые, средние, большие, в том числе
широкоцитоплазменные), моноциты, вироциты, иммунобласты, плазмоциты.
При преобладании в мазке крови среди
мононуклеаров бластных клеток картина крови напоминает острый лейкоз. Однако в
отличие от острого лейкоза бластные клетки вскоре исчезают и появляются
вироциты, что совпадает с разгаром заболевания. Увеличивается количество
лимфоцитов. Параллельно с появлением лимфоцитоза развивается нейтропения, но
иногда вместо нейтропении в первые дни заболевания может наблюдаться
нейтрофильный лейкоцитоз с ядерным сдвигом влево, вплоть до миелоцитов и даже
миелобластов. Возможно наличие нейтрофильных гранулоцитов с дегенеративными
изменениями.
Нейтрофилез обычно временный, но может быть и
постоянным, и в таких случаях диагностика весьма затруднена. Количество
эозинофильных гранулоцитов в развернутом периоде заболевания уменьшается, а в
периоде выздоровления увеличивается. Число эритроцитов и тромбоцитов остается в
пределах нормы, что очень важно для дифференциации с острым лейкозом. Иногда
отмечается небольшая анемия. Только при наличии гемолиза уменьшение количества
эритроцитов может быть значительным. СОЭ нормальная или несколько повышенная.
Из атипичных форм инфекционного мононуклеоза по
гематологическим особенностям выделяют ложнолейкемическую, стертую
лейкопеническую, агранулоцитарную, или ложноагранулоцитарную, гранулоцитарную,
анемическую, геморрагическую, тромбоцитопеническую и др.
В большинстве случаев миелограмма при
инфекционном мононуклеозе остается нормальной или характеризуется некоторым
увеличением количества лимфоцитов и моноцитов. У некоторых больных в
костномозговом пунктате обнаруживаются гиперплазия ретикулярных клеток и
значительная лимфоплазмоцитарная реакция.
Описаны случаи лимфоидной метаплазии костного
мозга при инфекционном мононуклеозе. В пунктатах из лимфатических узлов и
селезенки наряду с лимфоцитами обнаруживается значительное количество крупных
ретикулогистиоцитарных, плазматических и плазматизированных клеток. Встречаются
вироциты, довольно часто наблюдаются клетки в состоянии митоза. Без учета
данных клиники и картины крови цитологическая картина пунктата может ввести в
заблуждение ввиду большого сходства с лимфосаркомой.
Морфология клеток агранулоцитарного ряда



Костный мозг: 1 - полихроматофильный нормобласт;
2 - макромиелобласт; 3 - промиелоцит эозинофильный; 4 - метамиелоцит
нейтрофильный (юный нейтрофил); 5 - микромиелобласт; 6 и 7 - метамиелоцит
нейтрофильный; 8 - нейтрофил сегментоядерный (2 и 3 класса); 9 - промиелоцит
нейтрофильный

Среди реакций миелоидного типа доминируют
промиелоцитарные нейтрофильные реакции. Резкий промиелоцитарный сдвиг в
пунктате костного мозга на фоне омоложения гранулоцитов крови может быть
обусловлен токсикоинфекцией, аллергическими реакциями лекарственного
происхождения, при выходе из иммунного агранулоцитоза.
Периферическая кровь при лейкемоидной реакции


Инфекционный лимфоцитоз
Интерпретация лейкограммы
Лейкемоидная реакция - изменение состава крови и
лейкограммы за счет значительного левого сдвига, т. е. увеличение количества
созревающих клеток костного мозга и «омоложение» лейкоцитарного состава. Как
правило, это указывает на глубокое и тяжелое нарушение в организме, вызвавшее
чаще всего истощение «резервного» фонда зрелых лейкоцитов в тканях и костном
мозге. Тяжелые лейкемоидные реакции возникают при бактериальных пневмониях,
тяжелых инфекционных заболеваниях, сепсисе, остром гемолизе, тяжелых интоксикациях
(экзо- и эндо-), злокачественных опухолях, особенно при их метастазировании в
костный мозг, после массивных кровотечений. Они всегда свидетельствуют о
напряженном кроветворении.
При нейтрофильном типе лейкемоидной реакции в
лейкограмме отмечается левый сдвиг до миелоцитов и промиелоцитов, а в костном
мозге раздражение гранулоцитарного ростка. Данный тип может развиваться у
больных как реакция на развитие абсцесса, сепсиса и других воспалительных,
инфекционных процессов и интоксикаций, острой кровопотери, при гемодиализе.
Увеличение количества эозинофилов (более 20 % -
эозинофильный тип) наблюдается при:
· гельминтозах (наиболее часто),
· лямблиозе,
· коллагенозах и системных васкулитах
(с-м Чарга-Стросса),
· аллергических реакциях,
· бронхиальной астме,
· различных опухолях,
· ЛГМ, лейкозах,
· органных эозинофилиях (легочных,
кожных, эозинофильных гастроэнтеритах, болезни Таратынова, фасциитах),
· болезни Крона,
· экземе,
· грибковых дерматозах,
· при приеме многих медикаментов,
· реже - при бактериальных и вирусных
инфекциях.
Лейкоцитоз с увеличением в периферической крови
моноцитов более 15 %, сопровождающийся при этом появлением промоноцитов -
моноцитарный тип лейкемоидной реакции, наблюдается при туберкулезе,
коллагенозах, гонорее, паразитарных инвазиях, инфекционном мононуклеозе.
Нарастание числа лимфоцитов крови до 70 % в
лейкограмме и более 14 % в к/м с увеличением л/у и селезенки наблюдается при
лимфоцитарной реакции и встречается при инфекциях (инфекционном мононуклеозе,
ветряной оспе, иерсиниозе, инфекционном лимфоцитозе), лекарственных
воздействиях, остром инфекционном лимфоцитозе, иммунобластной и реактивных
лимфоаденопатиях, коллагенозах, туберкулезе, болезни «кошачьей царапины».
Базофилия может встречаться при аллергии,
эндокринной патологии, коллагенозах, ЖДА. Отличие лейкемоидной реакции от
лейкемической заключается в отсутствии бластов.
Чаще всего лейкемоидные реакции длятся недолго
(пока действует патологический фактор раздражения ростка кроветворения) и
исчезают по мере оздоровления, а лейкемические изменения - прогрессируют.
Лейкоцитарная реакция должна оцениваться вместе
с характером изменений тромбоцитов и эритроцитов, так как они имеют одного
общего предшественника. Поэтому при угнетении (метаплазии или гипоплазии
костного мозга) следует ожидать трехростковую панцитопению: анемию, тромбопению
и нейтропению, - что требует исследования костного мозга, при котором не должен
выявляться опухолевый субстрат.
В случае раздражения костномозговой ткани
(гиперплазии) может отмечаться трехростковая полицитемия: эритроцитоз,
гранулоцитоз, тромбоцитоз. Точно так же должна оцениваться нейтропения при
гипорегенераторных анемиях.
Лейкемические изменения - изменения лейкограммы,
обусловленные появлением опухолевого клона лейкоцитов (бласты, лимфоциты,
промиелоциты и т. д.) в лейкограмме и увеличением их числа характерны для
лейкозов.
Пример: лейкоцитов - 20 • 109/л.

В этом варианте все клеточные элементы крови в
достаточном количестве и лейкоцитоз - только за счет бластов.
Раздел II
Ретикулоциты-молодые эритроциты, образующиеся
после потери нормобластами ядер. Характерной особенностью ретикулоцитов
является наличие в их цитоплазме зернисто-нитчатой субстанции (ретикулума),
представляющей агрегированные рибосомы и митохондрии.
Ретикулоциты обитают как в периферической крови
- так и костном мозге. Их доля повышается при ускорении эритропоэза, а при
замедлении -снижается.
У новорожденных ретикулоцитов больше, чем у
взрослого человека. Количество их прямо пропорционально скорости производства
эритроцитов в костном мозге. Подсчет производится для оценки активности
эритропоэза.
МОРФОЛОГИЯ И КЛИНИЧЕСКОЕ ЗНАЧЕНИЕ РЕТИКУЛОЦИТОВ
Ретикулоциты обычно крупнее, чем зрелые
эритроциты. Цитоплазма ретикулоцитов содержит базофильную сеточку (ретикулум) в
виде мелких зерен, отдельных нитей, клубочков и т.п., которая представляет
собой агрегированные рибосомы и митохондрии. Время созревания ретикулоцитов
составляет 4-5 дня, из них в течение 3 дней они созревают в периферической крови,
после чего становятся зрелыми эритроцитами.
Число ретикулоцитов в крови отражает
регенеративные свойства костного мозга. В случае усиленного разрушения
эритроцитов доля ретикулоцитов может превышать 50%. Резкое снижение количества
эритроцитов в периферической крови может привести к искусственному завышению
числа ретикулоцитов, так как последний рассчитывается в % от всех эритроцитов.
По степени зрелости различают 5 видов
ретикулоцитов:

Распределение ретикулоцитов по степени зрелости
в соответствии с содержанием ретикулофиламентозной субстанции
Классификация по Г. А. Алексееву, почти 80%
ретикулоцитов относится к IV - V группам.группа: базофильное вещество
располагается в виде венчика - «венчикообразные», преимущественно
ядросодержащие ретикулоциты (нормобласты).группа: базофильное вещество имеет
вид клубка или глыбки - «клубкообразные» или «глыбкообразные»
ретикулоциты.группа: базофильное вещество расположено в виде густой сеточки
«полносетчатые» ретикулоциты.группа: базофильное вещество имеет вид отдельных
нитей - «неполносетчатые» ретикулоциты.группа: базофильное вещество расположено
в виде отдельных мелких зернышек - «пылевидные» ретикулоциты.
В норме в периферической крови содержится 0,2 -
1% ретикулоцитов («%» - содержание ретикулоцитов от общего числа эритроцитов).
Данный показатель отражает возможность выхода ретикулоцитов в периферическую
кровь и их дальнейшее превращение в зрелые эритроциты (созревание), как вариант
нормы, уже в периферической крови (в течение нескольких часов). При нормальном
эритропоэзе большинство эритроцитов проходит стадию ретикулоцитов в костном
мозге.
Ретикулоциты разной степени зрелости при
аутоиммунной гемолитической анемии
Железодефицитная анемия. Периферическая кровь.
Окраска по Романовскому-Гимзе
Единичные ретикулоциты при железодефицитной
анемии
Для оценки тяжести анемий используют
«ретикулярный индекс»: % ретикулоцитов х гематокрит / 45 х 1,85, где 45 -
нормальный гематокрит, 1,85- количество суток, необходимых для поступления
новых ретикулоцитов в кровь. Если индекс < 2 - говорит о гипопролиферативном
компоненте анемии, если > 2-3, то происходит увеличение образования эритроцитов.
Некоторые авторы отмечают, что у женщин
количество ретикулоцитов несколько большее, чем у мужчин. У детей в первые дни
жизни количество ретикулоцитов по разным данным может достигать 5 - 10%, а
затем уменьшается.
Показания к назначению анализа на ретикулоциты:
Ø оценка активности эритропоэза при
состояниях, сопровождающихся гемолизом или кровопотерей;
Ø оценка способности костного мозга к
регенерации после цитотоксической терапии и трансплантации костного мозга;
Ø оценка восстановления синтеза эритропоэтина
после трансплантации почки;
Ø допинговый контроль у спортсменов
(прием эритропоэтина);
Ø диагностика неэффективного гемопоэза
или снижения продукции эритроцитов;
Ø дифференциальная диагностика анемий;
Ø детекция нарушения регенераторной
способности костного мозга при дефиците железа, витаминов B12, B6, фолатов,
меди и мониторинга соответствующей терапии;
Ø оценка реакции на терапию
эритропоэтином, эритросупрессорами.
Подготовка к анализу
· Кровь на исследования рекомендуется
сдавать натощак, пить можно только воду.
· После последнего приёма пищи должно
пройти не менее 8 часов.
· Взятие крови на исследование
необходимо проводить до начала приема лекарственных препаратов (если это
возможно) или не ранее чем через 1-2 недели после их отмены.
· За день до взятия крови ограничить
жирную и жареную пищу, не принимать алкоголь, исключить тяжёлые физические
нагрузки.
Факторы, влияющие на результаты анализа
· Недостаточное перемешивание крови с
антикоагулянтом или неправильный выбор антикоагулянта.
· Переливание крови незадолго до
анализа.
· Гемолиз пробы крови.
· Приём различных лекарственных
препаратов (кортикотропин, сульфаниламиды, противомалярийные препараты,
леводопа, азатиоприн, нестероидные анальгетики, хлорамфеникол, метотрексат,
фолиевая кислота, витамин В12, препараты железа, эритропоэтин).
Забор крови производят в пробирку с ЭДТА, можно
перемещать, но не встряхивать.
Окраска
Особенность окраски ретикулоцитов
<#"582974.files/image015.gif">
Первую каплю крови удаляют ваткой, а из второй
капли изготовляется мазок. Кровь необходимо использовать как можно быстрее,
пока она не претерпела изменений и не потеряла своих физических свойств.
Быстронаступающее свертывание крови делает приготовление мазка совершенно
невозможным.
Мазок не должен доходить ни до конца, ни до
краев предметного стекла. Поэтому капля крови должна быть диаметром не более
2-3 мм. Предметное шлифованное стекло, которым делается мазок, должно быть уже
стекла, на которое наносят мазок. Для этого углы шлифованного стекла обламывают
пинцетом. В целях приготовления мазка шлифованное стекло ставят перед каплей
крови под углом 45° и продвигают вперед до соприкосновения с ней. Когда кровь
равномерно распределится между обоими стеклами, быстрым движением делают мазок.
Практическая работа №2
Окраска ретикулоцитов в пробирке
Метод 1 - окраска ретикулоцитов в пробирке
бриллиантовым крезиловым синим.
Перед употреблением готовят в пробирке рабочий
раствор бриллиантового крезилового синего из расчета на каплю 1% раствора
оксалата калия 4 капли раствора краски бриллиантового крезилового синего. В
краску добавляют 0,04 мл крови (две пипетки до метки 0,02). Смесь тщательно, но
осторожно перемешивают и оставляют на 30 минут. Затем снова перемешивают и
готовят тонкие мазки.
Метод 2 - окраска ретикулоцитов в пробирке
азуром II.
В пробирку помещают 0,05 мл раствора краски азур
II и 0,2 мл крови. Смесь тщательно перемешивают и оставляют на 20 - 30 минут.
Снова перемешивают и готовят тонкие мазки.
Метод 3 - окраска ретикулоцитов в пробирке
азуром I.
В пробирку помещают 0,3 - 0,5 мл раствора краски
азур I и 5 - 6 капель крови пипеткой от аппарата Панченкова. Пробирку закрывают
резиновой пробкой, смесь тщательно, но осторожно перемешивают и оставляют на 1
- 1,5 часа (ретикулоциты окрашиваются лучше при экспозиции 1,5 - 3 часа).
Перемешивают и готовят тонкие мазки.
В настоящее время в продаже имеются готовые
красители для ретикулоцитов заводского изготовления. Окраска ретикулоцитов с их
помощью производится согласно прилагаемой инструкции.
Окраска ретикулоцитов на стекле
Метод 1 - окраска метиленовым синим.
Для исследования ретикулоцитов пользуются и
водным раствором метиленовой синьки 1:500.
На чистое, обезжиренное покровное стекло наносят
каплю раствора метиленовой синьки, кладут его на высушенный нефиксированный препарат
крови и сразу рассматривают иммерсией микроскопа.
Практическая работа №3
Проведите подсчет ретикулоцитов и расшифруйте
результат
Ретикулоциты в мазке крови

Молодые ретикулоциты содержат
небольшое количество гемоглобина и при окраске обычными гематологическими
методами (например, по Романовскому-Гимзе) окрашиваются как кислыми, так и
основными красителями и выглядят в мазке как полихроматофильные эритроциты
<#"582974.files/image018.gif">
где: RET% - содержание ретикулоцитов
в %, А - количество ретикулоцитов, выраженное в ‰, B - количество подсчитанных
эритроцитов (1000).
У здоровых людей число ретикулоцитов
в крови составляет 2-12‰, или 0,2-1,2%

Метод 2
Для облегчения подсчета
ретикулоцитов американские исследователи предлагают использовать калибровочный
диск Миллера. Устройство размещается в одном окуляре микроскопа.
Диск Миллера представляет собой два
квадрата; одна сторона малого квадрата (В) составляет 1/9 стороны большого (А).
Указанная область используется для подсчета ретикулоцитов стандартным методом.
Эритроциты подсчитываются в малом квадрате В, ретикулоциты подсчитываются в
большом квадрате А в 20 полях зрения. Таким образом определяется число
ретикулоцитов и эритроцитов.

Диск Миллера для подсчета количества
ретикулоцитов
При использовании диска Миллера
подсчет относительного количества ретикулоцитов производится по формуле

Показатель Retic # (абсолютное
количество ретикулоцитов - ARC) отражает количество ретикулоцитов в 1 л крови.
Расчет производят по формуле

где: RET# - абсолютное количество
ретикулоцитов, RET% - содержание ретикулоцитов в %, RBC - количество
эритроцитов у обследуемого пациента, выраженное в 10 12/л.
Референтные значения составляют от
10 до 110 х 10 9/л.
Эти параметры важны при мониторинге
состояния эритропоэза при трансплантации костного мозга и проведении
химиотерапии.
При выраженных колебаниях величины
гематокрита рассчитывают показатель СRC (corrected reticulocyte count -
скорректированный счет ретикулоцитов) по формуле:

где: CRC - скорректированный счет
ретикулоцитов: RET(%) - содержание ретикулоцитов в %, Hct - величина
гематокрита (л/л), 0,45 - значение гематокрита при нормальных показателях
крови.
В норме около 1% ретикулоцитов попадает в
периферическую кровь за 1 день и там дозревает до эритроцитов также в течение
одного дня. При стимуляции эритропоэтином сокращается время созревания
эритробластов и ретикулоцитов костного мозга с 3,5 дней в норме до 1,5-1 дня.
Как следствие увеличивается время циркуляции ретикулоцитов в периферической
крови. Это обязательно должно быть учтено при определении индекса продукции
ретикулоцитов - RPI (reticulocyte production index) (схема 1).
Схема 1. Ретикулоцитарный индекс (RPI)

Величину данного индекса рассчитывают по
формуле:

где: RPI - индекс продукции ретикулоцитов, RET%
- содержание ретикулоцитов в%, Hct - 0,45 - величина гематокрита при нормальных
показателях крови (л/л), время созревания ретикулоцитов (дни) (табл. 1).
Таблица 1. Время созревания ретикулоцитов при
анемии в зависимости от величины гематокрита

Индекс продукции ретикулоцитов рассчитывается
при выраженной анемии, что позволяет определить тип эритропоэза.
Снижение показателя ниже 2 свидетельствует о
неэффективном эритропоэзе, увеличение более 3 - о повышенной пролиферативной
активности костного мозга.
Микроскопический метод является достаточно
трудоемким, недостаточно стандартизирован, в значительной мере субъективен и
далеко не всегда позволяет увидеть незначительное количество зернисто-сетчатой
субстанции в клетках. Часто невысокое качество мазков крови, малое количество
анализируемых клеток и методические ошибки при выполнении исследования приводят
к значительным колебаниям величины коэффициента вариации от 25 до 50% и выше.
Интерпретация результатов исследования
Ретикулоцитарный индекс (РИ).
В норме РИ 1,0 - 3,0.
· РИ < 1 - указывает на
гипопролиферативную форму анемии.
· РИ > 3 - указывает на активацию
эритропоэза.
Единица измерения: %, х109/л
Референтные значения:
|
Возраст,
пол
|
Ретикулоциты,
%
|
Ретикулоциты,
х109/л.
|
|
Дети:
|
|
до
1 мес.
|
0,2
- 2,0
|
6,0
- 108,0
|
|
2
- 12 мес.
|
0,2
- 1,5
|
7,6
- 75,0
|
|
1
- 14 лет
|
0,2
- 1,7
|
7,6
- 91,8
|
|
Взрослые
(>14 лет):
|
|
женщины
|
0,5
- 2,1
|
19,5
- 111,3
|
|
мужчины
|
0,2
- 1,7
|
8,6
- 100,3
|
Повышение
· Кровопотеря или гемолиз эритроцитов.
· Гемолитическая анемия.
· Талассемия.
· Лечение В12-дефицитной анемии
(ретикулоцитарный криз на 5-8 день терапии витамином B12).
· Малярия.
· Эффективная терапия железодефицитных
анемий препаратами железа (8-12 день лечения).
· Острое кислородное голодание.
· Другие гематологические заболевания
(метастазы рака в костный мозг, полицитемия).
Снижение
· Апластическая анемия.
· Нелеченная B12-дефицитная анемия.
· Метастазы рака в кости.
· Алкоголизм.
· Гипопластическая анемия.
· Заболевания почек.
· Микседема.
· Аутоиммунные заболевания системы
кроветворения.
Задания для самостоятельной работы
Ситуационные задачи
Задача 1. У больной жалобы на общую слабость,
желтушность кожных покровов
Результаты исследования крови:
Эритроциты - 2,9*10 12 / л
Гемоглобин - 80 г/л
Цветовой показатель - 0,8
Лейкоциты - 8,0*10 9 /л
СОЭ - 30 мм/час
Лейкоцитарная формула в пределах нормы.
Ретикулоциты - 48%
Тромбоциты - 200*10 9 /л
Морфология эритроцитов -
микросфероцитоз «1»
пойкилоцитоз «1»
Содержание непрямого билирубина в сыворотке
крови - 24 мкмоль/л.
Реакция на уробилин в моче - «3»
Задания:
1. Какие изменения наблюдаются в общем анализе
крови и дополнительных исследованиях?
2. Для какого состояния характерны данные
изменения?
. С какой целью произведен подсчет
ретикулоцитов?
. Перечислите особенности окраски мазка
крови на ретикулоциты.
. Назовите причины увеличения уробилина в
моче и непрямого билирубина в сыворотке.
Ответ:
. Гипохромная анемия, ретикулоцитоз,
ускорение СОЭ, изменение морфологии эритроцитов. Увеличение содержания
непрямого билирубина в сыворотке, уробилина в моче.
. Данные изменения характерны для
гемолитической анемии.
. Для уточнения характера анемии, так как
для гемолитических анемий характерен ретикулоцитоз.
. Кровь на ретикулоциты окрашивают по
методу Алексеева (реактивы азур I
и азур II) или
бриллиантовым крезиловым синим. Особенность окраски ретикулоцитов в том, что
клетка воспринимает краску без фиксации, т.е. когда она, выведенная из
кровеносного русла, еще жива. Такая окраска называется суправитальной.
. При гемолитических состояниях
наблюдается усиленный гемолиз эритроцитов, поэтому в сыворотке увеличивается
общий билирубин за счет непрямого (связанного), а в моче увеличивается
количество уробилина (моча цвета “чая”).
Задача 2: Больной К. 47 лет, рентгенотехник,
поступил в клинику с подозрением на хроническую лучевую болезнь
Результаты общего анализа крови и дополнительных
методов исследования:
Эритроцитов - 3, 5 * 1012/ л.
Гемоглобин - 116 г/л.
Цветовой показатель - 0, 95.
СОЭ - 25 мм/ч.
Лейкоцитов - 2,5 * 109/л.
Э П С Л М
5 39 50 5
Ретикулоциты - 0,7%.
Тромбоциты - 75 * 109/л.
Задания:
1. Какие изменения наблюдаются в результатах
общего анализа крови и дополнительных исследованиях?
2. Возможны ли данные результаты при
хронической лучевой болезни?
. С какой целью выполнен подсчет
количества ретикулоцитов?
. Назовите особенности окраски мазка
крови на тромбоциты.
Ответ:
. Нормохромная анемия, лейкопения,
увеличение СОЭ, тромбоцитопения, относительный лимфоцитоз, абсолютная
нейтропения.
. Да, так как при хронической лучевой
болезни в ОАК наблюдается снижение показателей гемоглобина и эритроцитов,
лейкоцитов. Нейтропения, относительный лимфоцитоз, увеличение СОЭ.
. Для оценки регенераторной способности
костного мозга (эритромиелоза).
. Окрашивают краской Романовского в
течение 1-2 часов.
Тесты
Вариант 1
. Повышение уровня ретикулоцитов в крови
характерно для:
а) хронической кровопотери
б) острой кровопотери
в) апластической анемии
г) все ответы верны
2. Если у больного имеется значительная
эозинофилия, то можно думать о:
а) паразитарной инфекции
б) узелковом периартрите
в) эозинофильном лейкозе
г) все варианты верны
. Лейкемоидные реакции
а) все ответы верны
б) могут быть миелоидного и лимфоцитарного типа
в) встречаются при септических состояниях
г) встречаются при иммунном гемолизе
. В большинстве случаев миелограмма при
инфекционном мононуклеозе
а) остается нормальной
б) наблюдается увеличение моноцитов
в) наблюдается уменьшение лимфоцитов
г) появляются бластные клетки
. Норма ретикулоцитов у женщин:
а) 0,5-2,7%
б) 0,5-2,1%
в) 1-3%
г) 2,1-3,4%
. Особенности ретикулоцитов:
а) наличие зернисто-сетчатой субстанции
б) наличие на переферии большого ядра
в) отсутствие зернистости
г) наличие включений
. Ретикулоциты окрашивают следующими
красителями:
а) р-р азура I
б) р-р Люголя
в) р-р бромтимолового синего
г) все ответы верны
. В лейкограмму входит все кроме:
а) моноцитов
б) лимфоцитов
в) тромбоцитов
г) эозинофилов
. Малосимптомный инфекционный лимфоцитоз
характерезуется:
а) увеличением базофилов
б) увеличением лимфоцитов
в) понижением моноцитов
г) все ответы верны
. Функции ретикулоцитов:
а) запуск немедленного гомеостаза
б) защитная
в) участвует в реакциях клеточного иммунитета
г) осуществляет синтез белка, гема, пуринов
Вариант 2
. Молодые эритроциты образующиеся после потери
нормобластами ядер, это:
а) тромбоциты
б) ретикулоциты
в) нормоциты
г) эритробласты
. Понижение уровня ретикулоцитов
характерно для:
а) глистные инвазии
б) прием цитостатиков
в) воспаление
г) интоксикация организма
. Среди реакций миелоидного типа
доминируют
а) промиелоцитарные нейтрофильные реакции
б) моноцитарные реакции
в) нейтрофильные реакции со сдвигом влево
г) реакции трех ростков миелопоэза
. Лейкемоидные реакции разделяются на следующие
кроме:
а) лимфоидные
б) лейкопенические
в)моноцитарные
г)миелоидные
. Ретикулоциты окрашивают следующими
красителями:
а) р-р Люголя
б) р-р метиленового синего
в) р-р бромтимолового синего
г) все ответы верны
6. Особенности ретикулоцитов:
а) наличие зернисто-сетчатой субстанции
б) наличие на переферии большого ядра
в) отсутствие зернистости
г) наличие включений
. Повышение ретикулоцитов сопровождается при:
а) кровопотерях
б) на фоне лечения В12 фолиеводиффецитной анемии
в) малярия
г)все ответы верны
. Норма ретикулоцитов у мужчин:
а)2-4%
б)0,5-0, 9%
в)0,2-1,7%
г)0,3-2,9%
. Симптомы инфекционного мононуклеоза
а) головная боль
б) ангина
в) зубная боль
г) все ответы верны
. Увеличение количества эозинофилов наблюдается
при:
а) гельминтозах
б) аллергиях
в) бронхиальной астме
г) все ответы верны
Список использованной литературы:
1. Руководство
по гематологии / Под ред. А.И. Воробьева. М.: Ньюдиамед, 2003.
2. Энциклопедия
клинических лабораторных тестов / Под ред. Н. Тица. М.: Ла-бинформ, 1997.
. Владимирская
Е.Б. Механизмы кроветворения и лейкемогенеза. М.: Династия, 2007.
4. Луговская С. А. Ретикулоциты / С. А.
Луговская, М. Е. Почтарь. - М., 2006.
5. Тареев Е. М. Анемия брайтиков / Е. М.
Тареев. - М., 1929.
6. NCCLS. Methods for
Reticulocyte Counting (Automated Blood Cell Counters, Flow Cytometry, and
Supravital Dyes); Approved Guideline. - 2nd еd.
NCCLS document H44-A2. - Wayne, Pennsylvania, 2004.
. Methods for Reticulocyte
Counting (Automated Blood Cell Counters, Flow Cytometry, and Supravital Dyes);
Approved Guideline. - 2nd еd.
- Vol. 24, № 8. 5. Алексеев Н. А. Анемии / Н. А.
Алексеев. - СПб. : Гиппократ, 2004. - 512 с.
. Энциклопедия клинических лабораторных
тестов / ред. Н. Тиц: пер. с англ. - М.: Лабинформ, 1997. - 960 с.
. Козинец Г. И. Кровь и инфекция / Г. И.
Козинец, В. В. Высоцкий, В. М. Погорелов [и др.]. - М. : Триада-Фарм, 2001. -
С. 98-101. 8. Приказ МЗ СССР № 1175 от 21.11.7.
. Любина А. Я., Ильичева Л. П. и соавторы
- "Клинические лабораторные исследования" - Москва,
"Медицина", 1984 г.
. Справочник по клиническим лабораторным
методам исследования. Под ред. Е. А. Кост. Москва "Медицина" 1975 г.
. Справочник "Лабораторные методы
исследования в клинике" под редакцией Меньшикова В. В. - Москва,
"Медицина", 1987 г
. Камышников В. С. Карманный справочник
врача по лабораторной диагностике - Москва, «МЕДпресс-информ», 2007 год.
. Шиффман Ф. Дж. М. Патофизиология крови.
М.: Бином, 2001.
. Руководство по гематологии / Под ред.
А.И. Воробьева. М.: Ньюдиамед, 2003.
16. Балуда,
В.П. Физиология системы гемостаза / В.П. Балуда [и др.]. - М., 1995.
17. Гематология: новейший справочник / под
ред. К.М. Абдулкодырова. - М., 2004. - С. 250-337.
18. Васина,
Н.И. Информационные ресурсы Internet/ Н.И. Васина; РРГУ.- М., 1999.